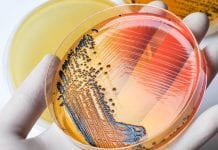

arthritis Related News
People living with arthritis are 20% less likely to work
New research shows that a typical person living with arthritis is 20% less likely to be in work than those without the condition.
Arthritis is...
High and low-dose exercise yields similar results for knee osteoarthritis
Researchers from Karolinska Institutet have compared high-dose exercise therapy to low-dose therapy in patients with knee osteoarthritis.
The research shows that both approaches to treating...
Older designs for knee replacements are as effective as new models
Older designs for knee replacements are equally as effective as newer models, according to new research from the Norfolk and Norwich University Hospital and...
Promising new treatment for hand osteoarthritis in early stages
Researchers from the University of Oxford have found that the drug talarozole, which increases retinoic acid, could offer new hope for hand osteoarthritis patients.
Hand...
AI can now be used to detect early knee osteoarthritis
Researchers have developed new Artificial Intelligence (AI) capable of detecting early knee osteoarthritis from x-ray images.
The new technology has been developed by the University...
Common workplace fumes may increase rheumatoid arthritis risk
Research suggests that breathing common workplace dust and fumes may heighten rheumatoid arthritis risk.
Rheumatoid arthritis is a long-term condition causing pain, swelling and stiffness...
A quarter of former Olympians have an osteoarthritis diagnosis
A study suggests that competing at an elite level in sports is linked to a future osteoarthritis diagnosis and joint pain.
One in four retired...
What is the best form of osteoarthritis treatment?
A new study has shown that patients with ankle osteoarthritis who undergo surgery see equally good outcomes from the two main forms of surgical...
One in five patients missed out on a rheumatoid arthritis diagnosis during COVID
A new study by Kings College London has found that the number of patients receiving their rheumatoid arthritis diagnosis fell by 20% in the...
Cases of inflammatory arthritis have increased by 40% since 2004
New research from Keele University has found that the proportion of adults in England diagnosed with inflammatory arthritis has increased by at least 40%...
Adopt a healthier lifestyle and ease osteoarthritis symptoms
New guidance from NICE: Healthy lifestyle choices such as exercising can help ease osteoarthritis symptoms.
Clinical evidence shows that a tailored exercise programme that includes...
Steroid injections provide relief for arthritis patients
A new study finds steroid injections can provide effective pain relief for patients with arthritis in their hip.
Steroid injections are anti-inflammatory medicines that treat...
Biomarker discovery may advance rheumatoid arthritis treatment
Scientists have identified novel biomarkers that may help design a new rheumatoid arthritis treatment, even predicting the condition before it develops.
A new study, published...
Research reveals exciting new treatment for inflammatory arthritis
A Canadian study has potentially identified a new and effective therapy for combatting a particularly severe form of inflammatory arthritis.
Researchers from the Schroeder Arthritis...
3D printed knee implants could cut surgery times and improve arthritis treatment
A new treatment has been developed using personalised, 3D printed implants to help improve the lives of thousands of arthritis sufferers.
Engineers from the University...
Salmonella linked to autoimmune responses, arthritis, and Alzheimer’s
New research has shown that Salmonella infections can cause autoimmune responses and arthritis in animals, and has presented a possible link to neurodegenerative diseases.
The...
The endocrine system: steroids put patients at high risk for COVID-19
Patients with endocrine system related diseases, and those who are taking a class of steroid medications called glucocorticoids, are at high risk for COVID-19.
The...
Molecule in lymphatic system implicated in autoimmune diseases
A new study has revealed how a molecule in the lymphatic system could have the potential to play a role in autoimmune diseases.
A study...
Painkiller alternative: is turmeric the answer for arthritis?
New research highlights that arthritis sufferers are looking for alternatives to painkillers and turmeric could be the answer
There are nearly ten million brits that...
Combination therapy for joint rejuvenation and preservation launched
A new combination therapy injection treatment has been launched that could provide a treatment option for people with arthritis and other similar conditions.
The Regenerative...